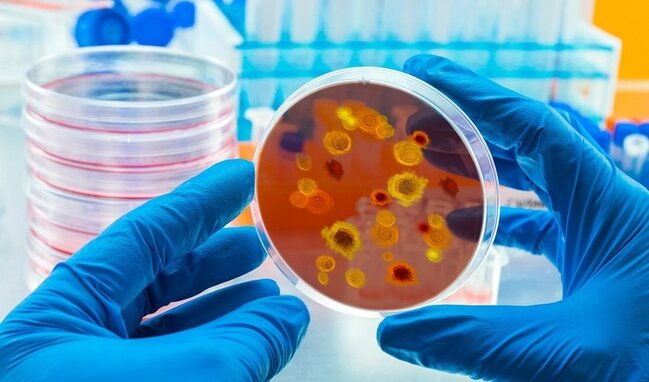

Qonşu ölkədə təhlükəli virusla bağlı XƏBƏRDARLIQ - Nazirlik əhaliyə ÇAĞIRIŞ ETDİ
 İranın səhiyyə nazirinin müavini Əlirza Rəisi ölkədə yeni koronavirus infeksiyası dalğası barədə xəbərdarlıq edib.
İranın səhiyyə nazirinin müavini Əlirza Rəisi ölkədə yeni koronavirus infeksiyası dalğası barədə xəbərdarlıq edib.
Musavat.com xəbər verir ki, bu barədə "Azad İran" telegram kanalı məlumat yayıb.
Nazir müavini insanları bir daha maskalardan istifadə etməyə çağırıb.
O, həm də ictimaiyyətin məlumatlandırılmasında medianı və məscidləri daha fəal rol oynamağa və ictimaiyyəti bu məsələyə ciddi yanaşmağa çağırıb.
Sonxeber.az
 Telegramda izləyin
Telegramda izləyin
Sosial Baxılıb: 1064 Tarix: 11 may 2025
Şikayətiniz varsa Whatsapp: 077 7125666
Facebookda Paylaş
Vəzifəli şəxslər küçə itlərinin yempulunu da mənimsəyiblər
Masallı Rayon Mənzil Kommunal Təsərrüfat İstehsalat Birliyinin (MKTİB) yeyintidə ittiham olunan vəzifəli şəxslərinin cinayət işi üzrə məhkəmə araşdırması başa çatıb. "Qafqazinfo"ya istinadən xəbər verir ki, Lənkəran Ağır Cinayətlər Məhkəməsində hökm oxunub. İş üzrə üç nəfər - MKTİB rəisi Məhərrə
10 iyunSabah pensiyalar ödəniləcək
İyunun 12-də Bakı və Sumqayıt şəhərləri, eləcə də Abşeron rayonu üzrə bu ayın pensiyalarının ödənilməsi nəzərdə tutulub. xəbər verir ki, bu barədə Əmək və Əhalinin Sosial Müdafiəsi Nazirliyi (ƏƏSMN) məlumat yayıb. Bildirilib ki, güzəştli şərtlərlə pensiya hüququna malik şəxslərin pensiyaları bu ay d
11 iyunPirşağıda qəzada 2 nəfər ağır yaralandı - Video
Paytaxtın Sabunçu rayonunun Pirşağı qəsəbəsində ağır yol qəzası baş verib. "Qafqazinfo" xəbər verir ki, hadisə zamanı "KiA" və "Nissan" markalı avtomobillər toqquşub. Nəticədə, iki nəfər (kişi və qadın) ağır xəsarət alıb. Yaralılar avtomobildən FHN əməkdaşlarının köməy
9 iyun33 dərəcə isti olacaq
Bakıda və Abşeron yarımadasında iyunun 10-da hava şəraitinin dəyişkən buludlu olacağı, əsasən yağmursuz keçəcəyi gözlənilir. Milli Hidrometeorologiya Xidmətindən -a verilən məlumata görə, şimal-şərq küləyi gündüz cənub-şərq küləyi ilə əvəz olunacaq. Havanın temperaturu gecə 17-19 isti, gündüz 27-32 ist
9 iyun6 gün leysan olacaq - XƏBƏRDARLIQ
Azərbaycanın rayonlarında iyunun 12-dən 17-dək hava şəraitinin bəzi yerlərdə fasilələrlə yağıntılı olacağı gözlənilir. xəbər verir ki, bu barədə Milli Hidrometeorologiya Xidməti məlumat yayıb. Bildirilib ki, ayrı-ayrı yerlərdə yağıntının intensiv olacağı, şimşək çaxacağı, dolu düşəcəyi, bəzi dağlıq v
11 iyun"Azərlotereya" ilə möhtəşəm əyləncə geri qayıdır!
Ölkənin qanuni lotereya təşkilatçısı və idman mərc oyunları operatoru "Azərlotereya" bu yay yenidən rəngarəng və həyəcan dolu layihəsi ilə görüşünüzə gəlir. "Şans Karvanı 2" musiqi, əyləncə və hədiyyələrlə zəngin interaktiv yay kampaniyası olaraq bu il Bakıdan start götürür və ölkəni
10 iyunQubada BƏDBƏXT HADİSƏ - Ölən var
Quba rayonunda 74 yaşlı kişi bədbəxt hadisə nəticəsində ölüb. -ın məlumatına görə, hadisə iyunun 10-da axşam saatlarında rayonun Cağacuq kəndində baş verib. Kənd sakini 1952-ci il təvəllüdlü Əşrəf Baloğlanov yaşadığı evin həyətyanı sahəsindəki yarımtikilidə dəmir borunu kəsərkən laqunda ehtiyatsızlıqda
11 iyun İranın səhiyyə nazirinin müavini Əlirza Rəisi ölkədə yeni koronavirus infeksiyası dalğası barədə xəbərdarlıq edib.
İranın səhiyyə nazirinin müavini Əlirza Rəisi ölkədə yeni koronavirus infeksiyası dalğası barədə xəbərdarlıq edib. Telegramda izləyin
Telegramda izləyin












 "Son zəng"də bunlar qadağandır (RƏSMİ)
"Son zəng"də bunlar qadağandır (RƏSMİ) Müzakirələrə səbəb olan foto silindi
Müzakirələrə səbəb olan foto silindi Pensiya və maaşları istənilən bankdan almaq mümkün olacaq
Pensiya və maaşları istənilən bankdan almaq mümkün olacaq Uşaqlarına bu adları qoyan ailələrə qızıl hədiyyə ediləcək
Uşaqlarına bu adları qoyan ailələrə qızıl hədiyyə ediləcək Fironların mirası: Liviya səhrası şüşəsinin sirri açılır
Fironların mirası: Liviya səhrası şüşəsinin sirri açılır Ramil Şeydayevin yeni klubu bəlli oldu
Ramil Şeydayevin yeni klubu bəlli oldu Yerin yaxınlığından güclü maqnit qasırğası yaradan plazma buludu keçib
Yerin yaxınlığından güclü maqnit qasırğası yaradan plazma buludu keçib Niyə yuxu görürük? - 4 elmi fərziyyə, biri qorxuludur
Niyə yuxu görürük? - 4 elmi fərziyyə, biri qorxuludur Tarkanın konsertində bu hərəkəti BƏYƏNİLDİ - VİDEO
Tarkanın konsertində bu hərəkəti BƏYƏNİLDİ - VİDEO Alimlər nə qədər yaşayacağımızı hesablamağı tapdılar
Alimlər nə qədər yaşayacağımızı hesablamağı tapdılar Aybəniz Haşımovaya nə olub?
Aybəniz Haşımovaya nə olub? Azov dənizində öldürülən azərbaycanlıların cənazələri ölkəyə gətirildi
Azov dənizində öldürülən azərbaycanlıların cənazələri ölkəyə gətirildi Hacıqabulda açıq ərazidə yanğın baş verib
Hacıqabulda açıq ərazidə yanğın baş verib Bu institut ləğv edilir
Bu institut ləğv edilir